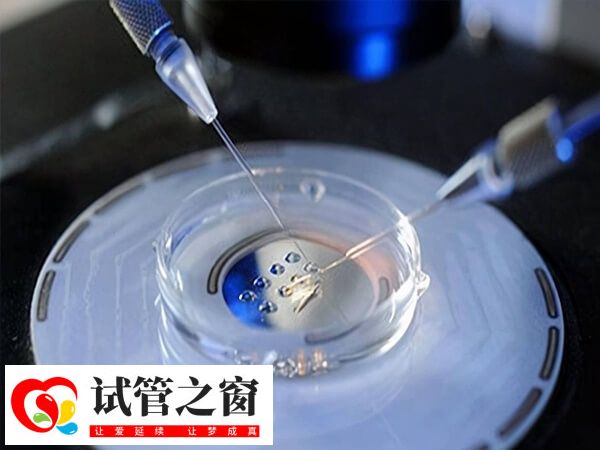
試管方案和試管移植的過程是不一樣的

拮抗劑方案等多久移植
拮抗劑方案的移植時間因移植類型不同而有所差異,一般患者若是在拮抗劑方案促排取卵后,身體狀態較好,且胚胎培養發育較好,那么可以選擇第三天的鮮胚或是第五六天的囊胚移植,以此縮短試管診療的時間。但如果患者促排取卵后,存在卵巢過度刺激或是其它影響,那么就可能需要等1個月左右進行凍胚移植。

拮抗劑方案的移植時間
試管方案和試管移植的過程是不一樣的,試管拮抗劑方案是試管促排卵方案中的一種。而對于試管移植的方案類型是指在取卵受精后對于移植胚胎類型的選擇。對于試管移植的胚胎類型有以下幾種:
1、囊胚移植
試管嬰兒常規治療中,一般采取第三天移植2-3個胚胎的移植方案,這時的胚胎一般發育到8-10細胞,如將胚胎繼續培養至第5-6天,即可發育到囊胚階段,這個時候移植的就是囊胚。
2、凍胚移植
在試管嬰兒過程中,促排多個卵子會培育多個胚胎,鮮胚移植時會挑選2-3個,把剩余的優質胚胎冷凍保存起來,在-196℃的液氮中進行保存,在需要時進行復蘇移植。
- 冷凍胚胎自然周期移植:優勢卵泡已排,內膜大于等于7mm,排卵后第3天或者第5天就是移植的最佳時間;
- 冷凍胚胎人工周期移植:內膜大于等于7mm,雌二醇100pg/ml以上,黃體酮轉化內膜4天或6天就是最佳移植時間。
3、鮮胚移植
如果女性身體素質較好,卵泡發育情況良好,且卵泡未出現明顯異常,雌二醇低于5000pg/ml,取卵數少于20個,沒有卵巢過度刺激傾向,內膜均勻且厚度在8mm以上等,一般可以在取卵后的第3天進行移植。





